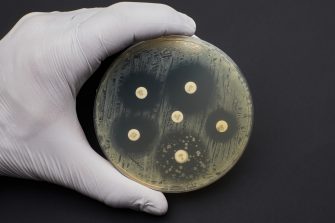
Antibiotic Sensitivity Test. Methods in Detecting Antimicrobial Resistance using petri dish. multidrug resistance

Research groups

Our research focuses on a diverse range of topics and disciplines including basic, applied, and clinical research into the science of vision. We conduct world leading, multidisciplinary research ensuring translational outcomes and significant improvements in ocular health.

.cropimg.width=335.crop=basic.jpg)